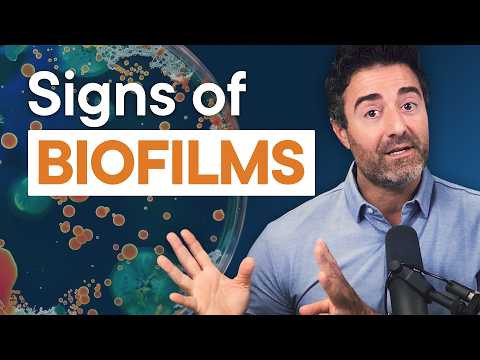
SIBO & Candida Biofilms; 3 Warning Signs

About 83 results for "UCRSG-nLPicq1r8uyM0zLMwA" - Time taken: 204 ms
Featured Results

PT24M51S
Proven Treatments for Ulcerative Colitis & Crohn’s (Research-Backed)
Dr. Michael Ruscio, DC, DNMOct 28, 2025
PT33M7S
Top 7 Foods To Eat EVERY DAY For Leaky Gut (Research-Backed)
Dr. Michael Ruscio, DC, DNMOct 6, 2025
PT24M13S
How To Reverse Autoimmune Disease (Symptoms, Diet & Supplements)
Dr. Michael Ruscio, DC, DNMAug 15, 2025
PT24M28S
Eat These Foods For SIBO, Candida & Histamine Intolerance
Dr. Michael Ruscio, DC, DNMAug 11, 2025
PT36M31S
Why You Have Abdominal Bloating & Pain – And How to Fix It
Dr. Michael Ruscio, DC, DNMJun 30, 2025
PT59M17S
Dr. Paul Anderson Reveals Hidden Blocks to Mitochondria Healing
Dr. Michael Ruscio, DC, DNMMay 12, 2025
PT38M46S
The Top Supplements To Boost Your Digestion & Gut Health
Dr. Michael Ruscio, DC, DNMMay 5, 2025
PT41M10S
4 Powerful Vagus Nerve Tools to Rewire Your Nervous System
Dr. Michael Ruscio, DC, DNMApr 28, 2025
PT47M15S
When SIBO Treatments Fail: Signs You Might Have Candida
Dr. Michael Ruscio, DC, DNMMar 24, 2025
PT28M42S
The Top Diet & Supplements For Healing Histamine Intolerance
Dr. Michael Ruscio, DC, DNMMar 17, 2025Swipe to view more pages